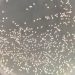
asma

A Organização Mundial do Comércio (OMC) analisou que as exportações feitas pela Ucrânia caíram 30% em termos de valor durante 2022, no contexto da guerra com a Rússia, com cereais sendo uma das commodities mais afetadas. Por outro lado, exportações russas subiram 15,6% no mesmo período de tempo, com destaque ao preço de combustíveis, fertilizantes e cereais.
Em relatório publicado nesta quinta-feira (23) que avalia o impacto provocado pelo conflito entre Ucrânia e Rússia no comércio internacional, a OMC afirmou que o crescimento do comércio ficou acima da taxa esperada pelo órgão de 3%.
“A estabilidade do comércio global foi evidente nas cadeias de suprimento, confirmado pelo crescimento anual de 4% do comércio de bens intermédios no segundo trimestre de 2022”, pontuou o relatório.
Apesar disso, a perda de valor de exportações ucranianas em 30%, em especial no âmbito de cereais, foi grave para países africanos que dependem da commodity. A Etiópia, por exemplo, importava 45% de seu trigo da Ucrânia e da Rússia, o que mudou em 2022 com a guerra, levando o país a importar dos Estados Unidos e Argentina.
Valor das exportações russas subiu, porém, a OMC argumenta que seu volume de exportação pode ter “diminuído ligeiramente”. “Os fluxos comerciais caíram acentuadamente para bens industriais, como veículos motorizados, produtos farmacêuticos ou aeronaves, onde as sanções são mais restritivas”, concluiu a análise.
Fonte: Estadão Conteúdo
Clique AQUI, entre no grupo de WhatsApp da Visão Agro e receba notícias em tempo real ou nos acompanhe através do Telegram